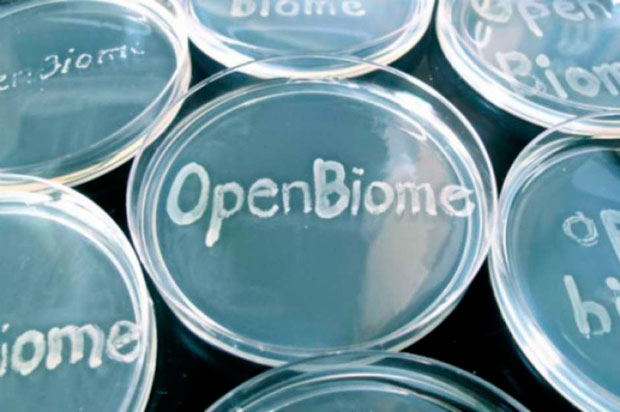

Nos Estados Unidos, uma organização está a procura de pessoas que fazem merda, a pessoa pode ganhar até R$ 35 mil por ano, já imaginou você fazendo cocô e ganhar essa bolada anualmente?
Nos Estados Unidos, uma organização está a procura de pessoas que fazem merda, a pessoa pode ganhar até R$ 35 mil por ano, já imaginou você fazendo cocô e ganhar essa bolada anualmente?
Nos Estados Unidos já é comum remunerar as pessoas por fazerem doações de sangue, óvulos, sêmen e aí por diante. O OpenBiome buscar ajudar as pessoas que sofrem com um distúrbio de colite pseudomembranosa, uma doença que causa diarreias persistentes da qual pode levar a pessoa a uma desidratação ou infecção generalizada, que é causada pela bactéria Clostridium difficile, que são bem resistentes a antibióticos.
O tratamento consiste em processar fezes saudáveis no estomago do paciente via endoscopia, tubos nasais ou capsulas
As pessoas que queiram aderir a esse banco, e vender suas fezes, poderá ganhar um valor equivalente `R$ 110 por amostra, e se o doador for fiel, ainda ganha um adicional, mais R$ 130. Com isso é possível conseguir R$ 680 por semana.
Mas tem algumas regras para a pessoa ser aprovada, existe uma avaliação clínica que contém 109 requisitos, depois se a pessoa passar pela avaliação clínica, deverá passar pela avaliação laboratorial e garantir que a pessoa está em perfeitas condições.
Créditos: The Washington Post
